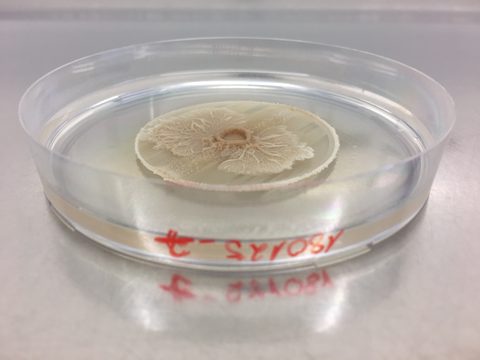
Bacillus subtilis BRAIN Biotech 2

The pharmaceutical and life sciences industries are at a turning point. As demand for enzyme-based solutions grows - spanning everything from biopharmaceuticals to diagnostic reagents - companies must find ways to rapidly scale up enzyme production while ensuring efficiency, regulatory compliance, and cost-effectiveness.
In our previous article, we discussed how production strains are central to enzyme scale-up and how BRAINBiocatalysts’ Plug & Produce platform is helping businesses overcome commercialisation hurdles. But behind every successful fermentation platform lies an essential foundation: advanced strain engineering and optimisation.
This is where BRAINBiocatalysts, a leader in biotechnology R&D, plays a crucial role. With R&D excellence in Germany and the state-of-the-art fermentation facility in the UK, BRAINBiocatalysts is pioneering the development of next-generation microbial strains delivering high-yield, efficient, and scalable production systems that meet the strict demands of the pharmaceutical and life science industries.
Unlike industrial enzymes used in food or chemicals, pharmaceutical and life science enzymes require exceptional purity, stability, and performance under strict regulatory conditions. This means that developing the right microbial host strain is not just about improving yields - it’s about creating a strain that can reliably produce the enzyme while meeting industry-specific quality and compliance requirements.
Strain engineering is the foundation of efficient, scalable, and commercially viable enzyme production. It involves:
For companies innovating in the pharmaceutical and life sciences markets, these factors are critical. Any variability in enzyme production can affect drug formulation, diagnostic accuracy, or bioprocess efficiency, making it essential to work with strains engineered for precision and reliability. This is where BRAINBiocatalysts’ expertise in strain development sets a new industry standard. BRAINBiocatalysts: Unlocking New Capabilities in Strain Engineering BRAINBiocatalysts has built a reputation as a global leader in biotechnology R&D, specialising in enzyme discovery, microbial strain engineering, and bioprocess optimisation. With deep expertise in synthetic biology, genome editing, and microbial expression, BRAINBiocatalysts is helping pharmaceutical and life science companies bridge the gap between enzyme discovery and full-scale production. Key Capabilities of BRAINBiocatalysts in Strain Engineering
This is where BRAINBiocatalysts’ expertise in strain development sets a new industry standard.
BRAINBiocatalysts has built a reputation as a global leader in biotechnology R&D, specialising in enzyme discovery, microbial strain engineering, and bioprocess optimisation. With deep expertise in synthetic biology, genome editing, and microbial expression, BRAINBiocatalysts is helping pharmaceutical and life science companies bridge the gap between enzyme discovery and full-scale production.
Key Capabilities of BRAINBiocatalysts in Strain Engineering
1. Tailored Host Development for High-Performance Enzyme Production
BRAINBiocatalysts designs and optimises bacteria, fungi, and yeast that deliver high-yield, efficient enzyme production.
These strains are engineered to minimise by-products, reduce metabolic stress, and enhance protein folding efficiency, critical for pharmaceutical applications where enzyme purity and activity are paramount.
2. Genome Editing & Synthetic Biology for Precision Engineering
Using advanced tools like CRISPR/Cas genome editing, BRAINBiocatalysts can fine-tune microbial pathways to optimise enzyme production yields, stability, and processing characteristics. Strains are engineered to channel metabolic resources more effectively, ensuring that fermentation processes produce higher enzyme yields with lower costs.
This means less waste, lower energy consumption, and improved sustainability - critical considerations to reduce costs and environmental impact. This approach allows for the development of tailored enzyme-producing strains that meet specific pharmaceutical and life science needs.
3. Scalability & Industrial Readiness
Unlike academic R&D solutions that focus on small-scale research, BRAINBiocatalysts ensures that all strains are optimised for industrial-scale fermentation, allowing seamless integration into large-scale pharmaceutical and life science production processes.
Strains developed by BRAINBiocatalysts transition easily into the Plug & Produce platform, offering a direct path to commercial-scale manufacturing.
4. Regulatory-Compliant Microbial Strains for Commercial Production
The pharmaceutical and life science industries require strict regulatory oversight. BRAINBiocatalysts ensures that all engineered strains are designed to meet industry standards, enabling easy adoption for drug development, bioprocessing, and diagnostic enzyme applications.
Meeting the Growing Needs of the Pharmaceutical & Life Science Markets
The increasing demand for therapeutic enzymes, biopharmaceutical production, and diagnostic reagents means that pharmaceutical and life science companies must move faster than ever to scale their enzyme manufacturing.
With BRAINBiocatalysts’ expertise in strain engineering and optimisation, companies can:
✔ Accelerate time to market – Reducing enzyme development cycles from years to months.
✔ Increase production efficiency – Achieving higher enzyme yields with lower costs.
✔ Ensure batch-to-batch consistency – Meeting stringent pharmaceutical quality and regulatory requirements.
✔ Reduce manufacturing risks – Offering a reliable and scalable fermentation solution.
By combining BRAINBiocatalysts’ advanced strain engineering capabilities with the Plug & Produce platform, companies gain a fully integrated solution - from strain development to large-scale commercial enzyme production.